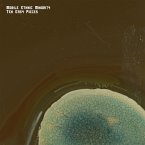

Produktdetails
- Anzahl: 1 Vinyl
- Erscheinungstermin: 20. Oktober 2017
- Hersteller: Galileo Music Communication Gm / SFA Distribution,
- EAN: 0641243800349
- Artikelnr.: 49127215
Hinweis: Dieser Artikel kann nur an eine deutsche Lieferadresse ausgeliefert werden.
- Herstellerkennzeichnung
- Galileo Music Communication GmbH
- Dachauer Str. 5-7
- 82256 Fürstenfeldbruck